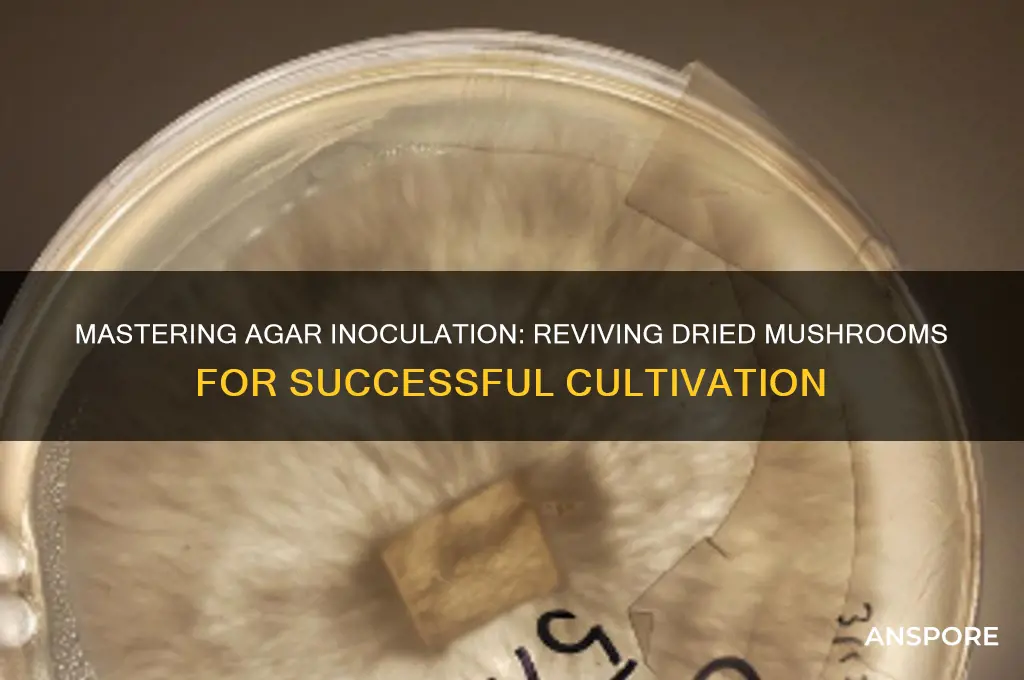
how to innoculate agar with dried mushroom

Inoculating agar with dried mushrooms is a precise process used in mycology to cultivate fungal cultures for research, preservation, or cultivation purposes. The method involves rehydrating dried mushroom tissue or spores and transferring them onto a nutrient-rich agar medium, which provides an ideal environment for fungal growth. To begin, the dried mushroom material is sterilized to prevent contamination, often by briefly flaming or using a sterile technique. The agar plates, prepared with a suitable substrate like potato dextrose agar or malt extract agar, must also be sterile. A small piece of the rehydrated mushroom or spore solution is then carefully introduced to the agar surface using a sterilized inoculation loop or needle. The plate is sealed and incubated under controlled conditions, typically at room temperature or slightly warmer, to encourage mycelial growth. This technique is essential for studying mushroom genetics, preserving rare species, or initiating mushroom cultivation projects, ensuring a clean and viable fungal culture.
| Characteristics | Values |
|---|---|
| Sterilization | Autoclave agar at 121°C (250°F) for 30-45 minutes or pressure cook. |
| Agar Medium | Use potato dextrose agar (PDA) or malt extract agar (MEA). |
| Dried Mushroom Preparation | Rehydrate dried mushrooms in sterile distilled water for 10-20 minutes. |
| Inoculation Tool | Use a sterile scalpel or inoculation loop. |
| Transfer Technique | Aseptically transfer a small piece of rehydrated mushroom to agar. |
| Incubation Temperature | Incubate at 22-28°C (72-82°F) in a dark or low-light environment. |
| Incubation Duration | Allow 7-14 days for mycelium growth. |
| Contamination Prevention | Work in a sterile environment (glove box or laminar flow hood). |
| Storage of Inoculated Agar | Store in a sealed container or petri dish at 4°C (39°F) if not in use. |
| Mycelium Transfer | Once grown, transfer mycelium to grain spawn or substrate. |
| Rehydration Liquid | Use sterile distilled water or 1% hydrogen peroxide solution. |
| Agar pH | Maintain pH 5.5-6.0 for optimal fungal growth. |
| Humidity Control | Keep incubation area at 60-70% humidity. |
| Documentation | Label agar plates with date, mushroom species, and source. |
Explore related products
What You'll Learn
- Prepare Agar Medium: Sterilize agar, cool to 50°C, and pour into sterile Petri dishes
- Rehydrate Mushroom Spores: Mix dried mushroom spores with sterile water in a vial
- Sterilize Tools: Flame-sterilize inoculation loop or needle before transferring spores
- Inoculate Agar: Dip tool into spore solution, streak onto agar surface in patterns
- Incubate Properly: Seal plates, store in dark at 22-26°C for 7-14 days

Prepare Agar Medium: Sterilize agar, cool to 50°C, and pour into sterile Petri dishes
To prepare the agar medium for inoculating with dried mushroom spores, begin by sterilizing the agar. This is a critical step to ensure that no contaminants interfere with the growth of your mushroom mycelium. Start by measuring the appropriate amount of agar powder and distilled water according to the recipe or instructions provided with your agar mix. Combine the agar powder and water in a heat-resistant container, such as an Erlenmeyer flask or a Pyrex pitcher. Stir the mixture thoroughly to ensure the agar is fully dissolved. Next, transfer the container to an autoclave, which is a specialized device designed to sterilize materials using high-pressure steam. Set the autoclave to run for at least 20-30 minutes at 121°C (250°F) to effectively kill any bacteria, fungi, or other microorganisms present in the agar mixture.
Once the sterilization process is complete, carefully remove the container from the autoclave and allow it to cool down. It’s essential to handle the container with care, as it will be extremely hot. Place it on a heat-resistant surface and let it cool to approximately 50°C (122°F). This temperature is crucial because pouring the agar at a higher temperature can damage the Petri dishes or cause the agar to solidify too quickly, while pouring it at a lower temperature may result in uneven setting. You can monitor the temperature using a thermometer or by testing the container’s exterior—it should be warm but not scalding to the touch.
While the agar is cooling, prepare your sterile Petri dishes. Ensure that the dishes are clean and free of any dust or debris. If they are not pre-sterilized, you can sterilize them in the autoclave alongside the agar mixture or use a different sterilization method, such as dry heat in an oven. Arrange the Petri dishes on a clean, sterile surface, preferably in a laminar flow hood or a still-air box to minimize the risk of contamination. If you don’t have access to specialized equipment, work in a clean area and ensure your hands and tools are sterilized using alcohol wipes or a flame.
Once the agar has cooled to 50°C, carefully pour it into the sterile Petri dishes. Hold the container close to the dish to minimize the exposure of the agar to the air, reducing the risk of contamination. Pour enough agar to create a thin, even layer across the bottom of each dish, typically around 10-15 mL per standard-sized Petri dish. Work quickly but carefully, as the agar will begin to solidify as it cools further. If you’re preparing multiple dishes, pour one at a time to maintain control over the process and ensure consistency.
After pouring the agar, allow the Petri dishes to sit undisturbed in a clean, sterile environment until the agar fully solidifies. This usually takes about 30-60 minutes, depending on the room temperature and the thickness of the agar layer. Once solidified, inspect the dishes for any signs of contamination, such as discoloration or unusual spots. Properly prepared agar should appear clear and free of impurities. The dishes are now ready for inoculation with your dried mushroom spores, ensuring a sterile and conducive environment for mycelial growth.
Mushroom Harvest Season: When to Pick Your Fungi
You may want to see also

Rehydrate Mushroom Spores: Mix dried mushroom spores with sterile water in a vial
To begin the process of rehydrating mushroom spores, gather your materials: a vial of dried mushroom spores, sterile distilled water, a sterile syringe, and a laminar flow hood or a clean, controlled environment to minimize contamination. Ensure all equipment is properly sterilized to maintain a contamination-free process. The goal is to create a spore solution that can be used to inoculate agar, so precision and sterility are crucial.
Start by preparing the sterile water. Measure out a small volume of sterile distilled water, typically 10-20 milliliters, depending on the size of the vial and the amount of spores. Draw the water into the sterile syringe, ensuring there are no air bubbles. The water should be at room temperature to prevent shocking the spores. Gently attach a sterile needle to the syringe, keeping the setup as clean as possible. If working in a laminar flow hood, turn it on and allow it to create a sterile airflow before proceeding.
Next, carefully open the vial containing the dried mushroom spores. This should be done swiftly but gently to minimize exposure to potential contaminants. Insert the needle through the septum of the vial, ensuring it reaches the bottom where the spores are located. Slowly inject the sterile water into the vial, allowing it to mix with the dried spores. Avoid vigorous shaking or stirring, as this can damage the delicate spores. Instead, gently tilt the vial back and forth to encourage even rehydration.
Allow the mixture to sit for a few minutes to ensure the spores are fully rehydrated. During this time, the spores will absorb the water and return to a viable state, ready for inoculation. Once rehydrated, carefully withdraw the spore solution into the syringe, leaving any debris or sediment behind. This ensures that only the viable spores are transferred to the agar. The syringe now contains a sterile, rehydrated spore solution ready for the next step in the inoculation process.
Finally, secure the syringe with the spore solution in a clean, sterile environment until you are ready to inoculate the agar. Proper handling and storage of the spore solution are essential to prevent contamination and ensure successful inoculation. With the spores now rehydrated and prepared, you can proceed to the next stage of the process, which involves transferring the spore solution to the agar plate or slant. This step is foundational for cultivating mushrooms from dried spores, setting the stage for mycelial growth and eventual fruiting.
Recognizing Dried Mushrooms: A Beginner's Guide
You may want to see also

Sterilize Tools: Flame-sterilize inoculation loop or needle before transferring spores
Before transferring spores to agar, it is crucial to sterilize your inoculation tools to prevent contamination. Flame sterilization is a highly effective method for achieving this. Begin by preparing your workspace with a sterile environment, such as a laminar flow hood or a clean, draft-free area. Ensure your inoculation loop or needle is clean and free of debris. Hold the loop or needle in a flame from a Bunsen burner or alcohol lamp until it glows red hot. This process eliminates any microorganisms on the surface of the tool. Allow the tool to cool slightly before use, as excessive heat can damage the agar or spores. Proper flame sterilization ensures that your inoculation tools are free from contaminants, setting the stage for a successful transfer.
To flame-sterilize effectively, hold the inoculation loop or needle at a 45-degree angle in the flame. This ensures even heating and thorough sterilization of the entire surface. Avoid touching any surface or object with the tool after sterilization, as this can reintroduce contaminants. If using a needle, ensure the entire length, including the tip, is exposed to the flame. For inoculation loops, focus on the wire loop itself, as this is the part that will come into contact with the spores and agar. Consistency is key—repeat the flame sterilization process each time you need to use the tool during the inoculation process.
After flame sterilization, allow the inoculation loop or needle to cool for a few seconds before use. You can test the temperature by gently touching the tool to the edge of the agar plate or a sterile surface. If it sizzles or melts the agar, it is still too hot. Proper cooling ensures that the tool does not damage the agar or spores during transfer. Remember, the goal is to maintain sterility while preserving the integrity of the materials you are working with.
During the inoculation process, maintain a sterile technique by minimizing exposure of the tool and agar to the environment. Work quickly but carefully to reduce the risk of contamination. If you notice any debris or residue on the tool after sterilization, repeat the flame sterilization process before proceeding. Consistency and attention to detail are essential for successful agar inoculation with dried mushroom spores.
Finally, dispose of or clean your inoculation tools properly after use. If disposable, place them in a biohazard container. If reusable, autoclave or thoroughly clean them before the next use. Flame sterilization is a critical step in the inoculation process, ensuring that your tools are free from contaminants and ready for precise spore transfer. By mastering this technique, you lay the foundation for healthy mycelial growth on your agar plates.
Mushroom Hunting in Illinois: A Beginner's Guide
You may want to see also
Explore related products
$14.95

Inoculate Agar: Dip tool into spore solution, streak onto agar surface in patterns
Inoculating agar with dried mushroom spores is a precise process that requires attention to detail and sterile technique. Begin by preparing your spore solution using dried mushroom spores. To do this, place a small amount of dried mushroom material into a sterile container with distilled water. Allow the spores to rehydrate and disperse naturally, or gently agitate the solution to help release the spores. Ensure all tools and containers are sterilized to prevent contamination. Once your spore solution is ready, you’ll need a sterile inoculation tool, such as a flame-sterilized inoculation loop or needle. Dip the tool into the spore solution, ensuring it picks up a small amount of the spore suspension. The goal is to transfer a controlled quantity of spores to the agar without overloading the surface.
Next, prepare your agar plate by ensuring it is properly solidified and at room temperature. Remove the lid of the agar plate in a sterile environment, such as a laminar flow hood or near a flame, to minimize airborne contaminants. Quickly but carefully, dip your inoculation tool into the spore solution again if necessary, and then streak it onto the agar surface in a deliberate pattern. Common patterns include the "T-streak" or "quadrant streak," which help distribute the spores evenly and create isolated colonies. Start by streaking one area of the agar, then flame-sterilize the tool again and repeat the process in another section, ensuring the tool only touches the agar surface briefly to avoid digging into the medium.
As you streak the agar, maintain a light touch to avoid damaging the agar surface. The goal is to create a thin layer of spores across the designated areas. After completing your streaks, immediately close the agar plate with its lid to prevent contamination. Properly label the plate with the date, spore source, and any other relevant information. Place the inoculated agar plate in an incubator set to the appropriate temperature for mushroom mycelium growth, typically around 22–28°C (72–82°F), and monitor it for signs of colonization over the next few days to weeks.
Sterility is critical throughout this process. Always flame-sterilize your inoculation tool between dips into the spore solution and between streaks on the agar. Work quickly but methodically to minimize exposure to contaminants. If you’re working without a laminar flow hood, create a makeshift sterile environment by sterilizing your workspace with alcohol and using a flame to keep the air clear of particles. Practice good aseptic technique, such as avoiding breathing directly over the plate and wearing clean gloves.
Finally, observe the agar plate regularly for signs of mycelial growth. Successful inoculation will result in visible colonies spreading across the agar surface. If contamination occurs, discard the plate and sterilize all tools before attempting the process again. With patience and precision, inoculating agar with dried mushroom spores can be a rewarding step in cultivating mushroom mycelium for further study or cultivation.
Understanding Mushroom Classification in RimWorld: A Comprehensive Guide
You may want to see also

Incubate Properly: Seal plates, store in dark at 22-26°C for 7-14 days
Once you've successfully inoculated your agar plates with dried mushroom spores, proper incubation is crucial for mycelium growth. Seal the plates tightly with micropore tape or parafilm to prevent contamination and maintain humidity. Ensure the seal is secure but not overly tight, as some air exchange is still necessary. Proper sealing also helps regulate the internal environment, promoting optimal growth conditions.
Store the sealed plates in a dark environment, as light can inhibit mycelium development and encourage contamination. A dark cabinet, closet, or dedicated incubation chamber works well. Avoid areas with direct sunlight or frequent light exposure. The darkness mimics the natural underground environment where many mushrooms thrive, encouraging healthy mycelium colonization.
Maintain a stable temperature between 22-26°C (72-78°F) during incubation. Fluctuations outside this range can slow growth or stress the mycelium. Use a thermometer to monitor the incubation area, and consider a heating pad or incubator if ambient temperatures are inconsistent. Avoid placing plates near heat sources or drafts, as these can create uneven temperatures.
Allow the plates to incubate undisturbed for 7-14 days, depending on the mushroom species and environmental conditions. Faster-growing varieties may show visible mycelium within a week, while slower species may take the full two weeks. Resist the urge to check the plates frequently, as opening them increases contamination risk and disrupts the internal environment. Patience is key during this stage.
After incubation, inspect the plates for healthy, white mycelium growth. If contamination is present (e.g., mold or bacteria), discard the plate to prevent spreading. Successfully colonized plates can be used for grain spawn or further cultivation. Proper incubation ensures a strong foundation for your mushroom cultivation project, setting the stage for successful fruiting in later stages.
Grow Your Own: A Guide to Psychedelic Mushrooms
You may want to see also
Frequently asked questions
Rehydrate the dried mushrooms in sterile distilled water at room temperature for 1-2 hours. Strain the liquid, and use a sterile scalpel or needle to transfer a small piece of the rehydrated mushroom tissue onto the agar.
Sterilize all equipment, including scalpels, needles, and containers, by autoclaving at 121°C (250°F) for 15-20 minutes. Alternatively, use 70% isopropyl alcohol to wipe down tools and flame sterilize metal instruments.
Use a nutrient-rich agar like potato dextrose agar (PDA) or malt extract agar (MEA), as they support mushroom mycelium growth. Ensure the agar is properly prepared and sterilized before inoculation.
Mycelium growth typically appears within 7-14 days, depending on the mushroom species and environmental conditions. Maintain the agar plate at a consistent temperature (22-26°C or 72-78°F) in a dark, sterile environment.

























